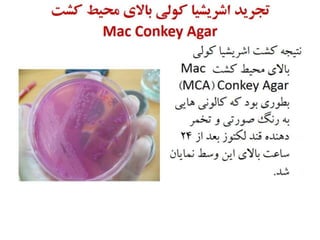
Colibacillosis
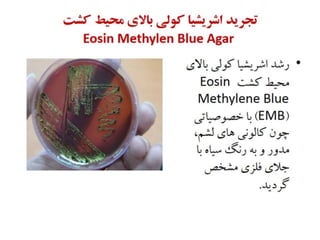
Colibacillosis

More Related Content
PDF
Artificial Intelligence, Data and Competition – SCHREPEL – June 2024 OECD dis... PDF
2024 Trend Updates: What Really Works In SEO & Content Marketing PDF
Storytelling For The Web: Integrate Storytelling in your Design Process PDF
How to Leverage AI to Boost Employee Wellness - Lydia Di Francesco - SocialHR... PDF
Everything You Need To Know About ChatGPT PDF
2024 State of Marketing Report – by Hubspot PPTX
Antimicrobial resistance shakhes PPTX
Recently uploaded
PDF
Agents in Artificial Intelligence: Types, Architecture and Real-World Examples PDF
Overview of Ethiopian Agriculture: Systems and Economic Impact.pdf PDF
BÀI GIẢNG POWERPOINT CHÍNH KHÓA PHIÊN BẢN AI TIẾNG ANH 6 CẢ NĂM, THEO TỪNG BÀ... PDF
BÀI GIẢNG POWERPOINT CHÍNH KHÓA PHIÊN BẢN AI TIẾNG ANH 6 CẢ NĂM, THEO TỪNG BÀ... PPTX
OCCULTISM IN JEHOVAH'S WITNESSES' ARTWORK PDF
Freshman Geography Chapter 7-Population of Ethiiopia PDF
Caribbean Examinations Council Literacy and Numeracy Standards PDF
The Unique Wildlife of Ethiopia: From the Simien to the Bale Mountains PPTX
Nanomaterials and its types - Dr.M.Jothimuniyandi PPTX
Redox Titration - Oxidation and Reduction PPTX
special senses-eye, ear, nose, tongue.pptx PDF
To synthesis and submit Benzamide synthesis.pdf PDF
Fanatics of LDM a Time Capsule By LDMMIA PPTX
Introduction Pharmacotherapeutics _ PT1 2026.pptx PPTX
Introduction of Carbohydrates - Dr.M.Jothimuniyandi PPTX
ANTISEPTICS AND DISINFECTANTS CHAPTER NO.05.pptx PPTX
ART aPPRECIATION - Lesson 1 AND 2 COVERAGE PPTX
VITAMINS CHAPTER NO.05 PHARMACOGNOSY D. PHARMACY PPTX
Allow Quantity Modification in Combo in Odoo 19 pos PPTX
ANTI-TUSSIVE CHAPTER NO.05 PHARMACOGNOSY Featured
PDF
Product Design Trends in 2024 | Teenage Engineerings PDF
Beginners Guide to TikTok for Search - Rachel Pearson - We are Tilt __ Bright... PDF
AI Trends in Creative Operations 2024 by Artwork Flow.pdf PDF
Social Media Marketing Trends 2024 // The Global Indie Insights PDF
PEPSICO Presentation to CAGNY Conference Feb 2024 PDF
How to have difficult conversations PDF
Unlocking the Power of ChatGPT and AI in Testing - A Real-World Look, present... PDF
Trends In Paid Search: Navigating The Digital Landscape In 2024 PDF
Google's Just Not That Into You: Understanding Core Updates & Search Intent PDF
ChatGPT and the Future of Work - Clark Boyd PDF
Getting into the tech field. what next PDF
PDF
Content Methodology: A Best Practices Report (Webinar) PDF
12 Ways to Increase Your Influence at Work PDF
5 Public speaking tips from TED - Visualized summary PDF
Introduction to Data Science PDF
The six step guide to practical project management PDF
How Race, Age and Gender Shape Attitudes Towards Mental Health PDF
Time Management & Productivity - Best Practices PPTX
How to Prepare For a Successful Job Search for 2024